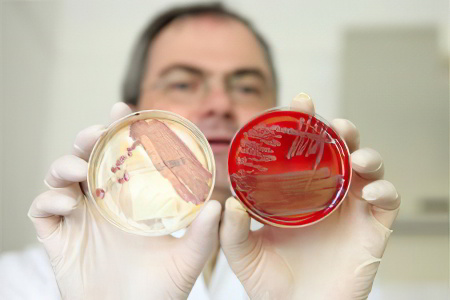

Причины дизентерии у взрослых и детей
Дизентерия передается от людей с острой и хронической формой инфекции, а также от бактерионосителей.
- Человек с острой формой дизентерии является высокозаразным, особенно в первые дни после появления симптомов. Острое течение заболевания может длиться до 3 месяцев, в течение которых инфицированный продолжает выделять патогенные микроорганизмы в окружающую среду.
- При хронической форме заболевания выделение шигелл происходит в периоды обострения, которые могут длиться до 3 месяцев.
- Бактерионосители могут выделять инфекционные агенты длительное время, при этом симптомы болезни могут быть неявными или отсутствовать.
Заражение дизентерией происходит из-за несоблюдения гигиенических норм и употребления загрязненных продуктов.
Инфекция передается фекально-оральным путем, который реализуется следующими способами:
- Через воду. Так распространяется дизентерия Флекснера.
- Алиментарным путем. Этот способ характерен для дизентерии Зоне.
- Контактно-бытовым путем. Этот путь распространения характерен для дизентерии Григорьева-Шига.
Несоблюдение правил личной гигиены и использование предметов быта, на которых находятся возбудители инфекции, обязательно приведет к заражению.
Распространителями инфекции также являются мухи. Бактерии могут находиться на продуктах питания (особенно опасны молочные изделия), фруктах и овощах, а также на грязных руках и предметах, которые использовал больной.
Люди имеют высокую восприимчивость к возбудителям дизентерии, независимо от возраста и пола. Однако чаще всего от заболевания страдают дети младшего возраста, что связано с недостаточной сформированностью навыков личной гигиены. Риск заражения увеличивается у людей с острыми и хроническими заболеваниями органов ЖКТ, а также с дисбактериозом кишечника.
Вспышки дизентерии чаще всего фиксируются в теплое время года: летом и осенью, когда условия для размножения патогенной флоры наиболее благоприятны.
После перенесенной дизентерии у человека вырабатывается иммунитет, который сохраняется в течение года и действует только против одного вида возбудителя, в то время как их существует множество.
Микрофлора, способная вызвать дизентерию, может оставаться активной до 45 дней. При попадании микробов в молочные и некоторые другие продукты они начинают размножаться.
Первые симптомы заболевания проявляются, когда микробы достигают кишечника и начинают делиться, выделяя токсические вещества. Эти токсины проникают в кровь и отравляют организм, негативно влияя на состояние печени, кишечника, сосудов и центральной нервной системы. При поражении тонкой кишки могут образовываться глубокие язвы.
Врачи отмечают, что дизентерия, хотя и считается заболеванием, преимущественно характерным для развивающихся стран, может встречаться и в более благополучных регионах. Специалисты подчеркивают, что у детей болезнь протекает тяжелее, чем у взрослых, что связано с особенностями иммунной системы и более высокой восприимчивостью к инфекциям. Врачи рекомендуют родителям быть особенно внимательными к симптомам, таким как частый понос, боли в животе и высокая температура. При подозрении на дизентерию важно незамедлительно обратиться за медицинской помощью, так как своевременная диагностика и лечение могут предотвратить серьезные осложнения. Врачи также акцентируют внимание на важности соблюдения гигиенических норм и правил питания, чтобы снизить риск заражения.

Симптомы дизентерии
С момента заражения до появления первых признаков заболевания проходит от нескольких часов до нескольких дней. В среднем инкубационный период составляет 2-3 дня.
Среди симптомов дизентерии выделяют:
- Острое начало с интоксикацией. У пациента повышается температура, возникают головные боли, тошнота и отсутствие аппетита. Также может наблюдаться снижение артериального давления.
- Боли в животе, локализующиеся в области пупка. Сначала они слабые и разлитые, но по мере размножения патогенных микроорганизмов становятся схваткообразными. Боль может распространяться на нижнюю часть живота и лобок, особенно интенсивно ощущается в левой части. При наполнении кишечника боль усиливается.
- Ложные позывы к дефекации. Поход в туалет не приводит к опорожнению кишечника. Возможны боли в прямой кишке, которые могут беспокоить пациента еще несколько минут после посещения туалета. Боль тянущая и может иррадиировать в область крестца.
- Увеличение частоты стула. Он может происходить более 10 раз в день, а в испражнениях могут быть видны кровяные прожилки и слизь.
В 20% случаев заболевание протекает по гастроэнтерическому типу. В этом случае повышение температуры и расстройства пищеварительной системы возникают одновременно, а стул становится жидким с самого начала. Начиная со второго дня болезни, у пациента могут проявляться симптомы колита. Из-за интенсивной диареи, часто сопровождающейся рвотой, у больного нарастают признаки дегидратации: он становится вялым и апатичным, артериальное давление снижается, а кожа и слизистые оболочки теряют влагу. Объем мочи уменьшается.
Протекание болезни может быть различным. Иногда дизентерия переносится легко, и у человека наблюдаются лишь слабость и недомогание. В других случаях заболевание требует госпитализации, так как сопровождается высокой температурой, бледностью кожи, постоянной рвотой и нарушениями в работе нервной системы.
Если заболевание переходит в хроническую форму, симптомы интоксикации отсутствуют. Однако развивается диарея, и испражнения приобретают зеленоватый оттенок. На фоне хронической нестабильности стула может возникнуть дисбактериоз. При своевременном и правильном лечении болезнь не переходит в хроническую стадию, что происходит только при отсутствии медицинской помощи.
| Симптом | Дети | Взрослые |
|---|---|---|
| Частота стула | Более 10 раз в день, часто с примесью слизи и крови | От 5 до 10 раз в день, часто с примесью слизи и крови |
| Характер стула | Жидкий, водянистый, иногда с примесью слизи, гноя и крови; может быть пенистым | Жидкий, водянистый, часто с примесью слизи и крови; может быть пенистым |
| Боль в животе | Спастические боли в животе, часто локализованные в левой подвздошной области | Спастические боли в животе, часто локализованные в левой подвздошной области, могут быть сильными |
| Лихорадка | Высокая температура (38-40°C) | Может быть умеренная лихорадка (37-38°C) или её отсутствие |
| Тошнота и рвота | Часто присутствуют | Может присутствовать |
| Общее состояние | Выраженная слабость, вялость, апатия, обезвоживание | Слабость, утомляемость, головная боль, обезвоживание |
| Обезвоживание | Быстро развивается, проявляется сухостью слизистых, снижением тургора кожи, тахикардией | Может развиваться, проявляется сухостью слизистых, снижением тургора кожи, тахикардией |
| Дополнительные симптомы у детей | Судороги (в тяжелых случаях), нарушение сознания |
Симптомы дизентерии у детей
У детей дизентерия проявляется иначе, чем у взрослых. У малышей наблюдаются общая интоксикация и боли в животе, но диарея не всегда развивается. Каловые массы выделяются в небольших количествах и всегда содержат кровь и слизь. Состояние ребенка ухудшается, температура тела повышается, появляется головная боль, и он отказывается от пищи. Колитический синдром с кровью в стуле наблюдается у 90% детей с дизентерией, однако его проявления не всегда имеют острое течение.
После первого дня болезни характер стула меняется. При опорожнении кишечника могут выделяться не каловые массы, а слизистые зеленоватые выделения с примесью крови.
Если у взрослых возникают ложные позывы к дефекации, то у детей наблюдается расслабление заднего прохода, повышенная тревожность и плач. У малышей младше трех лет живот может быть вздутым, в то время как у детей старшего возраста он может быть втянутым.
Токсическая форма заболевания у грудных детей встречается редко. Симптомы интоксикации у младенцев выражены слабо, так как их иммунная система не реагирует на токсины, выделяемые бактериями. Для грудных детей дизентерия опасна в первую очередь из-за риска обезвоживания. При жидком стуле и рвоте малыши теряют значительное количество жидкости, и дегидратация может развиваться очень быстро.
Водянистый стул и рвота приводят к потере веса, нарушая обменные процессы в организме. Это может вызвать проблемы с сердечно-сосудистой системой, парез кишечника и другие серьезные последствия для здоровья.
Симптомы стафилококковой дизентерии в сочетании с сальмонеллезной инфекцией могут проявляться следующими признаками:
- Илеоколит.
- Илеит.
- Лихорадка.
- Явная интоксикация.
- Постоянная рвота.
- Анорексия.
- Вздутие живота и зловонный стул.
При тяжелом течении болезни дизентерия может сопровождаться судорогами, обмороками, цианозом кожи, менингитом, тахикардией, аритмией, снижением артериального давления и приглушенностью сердечных тонов.
Дизентерия — это инфекционное заболевание, которое вызывает беспокойство как у родителей, так и у взрослых. Многие люди отмечают, что симптомы, такие как диарея, боли в животе и высокая температура, могут быть особенно тяжелыми для детей. Родители часто делятся опытом, как важно быстро обратиться к врачу, чтобы избежать осложнений. Взрослые также не застрахованы от этого недуга, и их отзывы подчеркивают необходимость соблюдения гигиенических норм, особенно в условиях массового скопления людей. Некоторые отмечают, что профилактика играет ключевую роль: регулярное мытье рук и употребление безопасной пищи могут значительно снизить риск заражения. В целом, общественное мнение подчеркивает важность осведомленности и своевременного лечения, чтобы минимизировать последствия заболевания.

Как отличить дизентерию от других кишечных расстройств?
Дизентерия может иметь схожие признаки с другими заболеваниями кишечника, поэтому важно знать их ключевые отличия:
- Сальмонеллез и пищевое отравление. Заболевание начинается с частой рвоты, которая может повторяться. Боль ощущается в области подложечной зоны. Спазмы с левой стороны живота отсутствуют, так как толстая кишка не затрагивается при пищевых отравлениях. Тенезмы также не наблюдаются. При сальмонеллезе каловые массы становятся зеленоватого оттенка и напоминают болотную тину.
- Амебиаз. Симптомы амебиаза менее выражены по сравнению с дизентерией. Температура может немного повышаться, но незначительно. В испражнениях присутствуют кровь и слизь, напоминающие малиновое желе. При анализе выделений можно обнаружить большое количество амеб.
- Холера. Первые признаки холеры включают диарею, обильную рвоту, небольшое повышение температуры и тенезмы. Каловые массы жидкие и напоминают рисовый отвар. Симптомы обезвоживания развиваются стремительно, что значительно ухудшает состояние пациента.
- Брюшной тиф. При этом заболевании наблюдается спастический колит, температура тела может значительно повышаться и сохраняться длительное время. На коже появляется сыпь в виде розеол.
- Колит. Это заболевание неинфекционного характера, возникающее на фоне химической интоксикации организма. Колит может сопровождать гастрит, холецистит, уремию и болезни тонкого кишечника. Обострения колита не зависят от времени года, болезнь не является заразной и не приводит к серьезным изменениям в органах пищеварительной системы.
- Геморрой. У пациента наблюдаются выделения крови из анального отверстия, однако воспаление толстого кишечника отсутствует. Кровь появляется только в конце акта дефекации.
- Рак прямой кишки. Симптомы интоксикации проявляются только на стадии распада опухоли. В этот период также появляется кровь и развивается диарея. Онкологические заболевания не имеют острого течения и могут давать метастазы в другие органы и лимфатические узлы.
Лечение дизентерии
Если заболевание возникает у ребенка младше трех лет, его необходимо госпитализировать. Взрослых пациентов можно оставить на амбулаторном лечении, если их состояние это позволяет.

Схема лечения:
- Фуразолидон — препарат первого выбора при легкой форме дизентерии. При осложнениях применяются антибиотики широкого спектра действия: фторхинолоны, цефалоспорины и аминогликозиды.
- С первого дня болезни важно начинать прием препаратов для предотвращения обезвоживания: Регидрон, Оралит, Глюкосолан. Один пакетик выбранного средства разводят в литре воды и дают ребенку по одной чайной ложке каждые 5 минут. Суточная доза рассчитывается по формуле 110 мл на 1 кг веса.
- Эубиотики помогают избежать дисбактериоза кишечника и должны приниматься не менее трех недель. К ним относятся Бифидумбактерин, Бифиформ, Линекс и Риофлора Иммуно.
- Врач может назначить средства для повышения иммунитета, витамины, спазмолитики и другие препараты.
- После купирования острого периода дизентерии необходимо использовать средства, способствующие регенерации слизистых оболочек. Для этого делают микроклизмы с маслами шиповника, облепихи, Винилином и отваром ромашки.
- Для выведения токсинов из организма подходят Смекта, Полисорб, Полифепан и Фильтрум СТИ.
- Для улучшения пищеварительных процессов можно использовать Фестал, Креон, Мезим и Панкреатин.
- Если заболевание переходит в хроническую стадию, пациенту рекомендуется физиотерапия, продолжение приема эубиотиков и микроклизм.
Во время лечения необходимо соблюдать диету. Больному следует предлагать слизистые супы, отвар риса, картофельное пюре и несолёные разваренные каши. Если ребенок отказывается от еды, не стоит его заставлять. Важно следить за тем, чтобы он пил достаточно воды. Также можно предложить чай без сахара или молочную сыворотку. Запрещены сдобные изделия, мясные блюда, кофе, полуфабрикаты, колбасы, копчености и сыры. С пятого дня болезни допускается введение в рацион кефира, тефтелей, омлета и отварной рыбы.
Вопрос-ответ
Как проявляется дизентерия у взрослых?
Комплекс симптомов при дизентерии включает в себя кашицеобразный или жидкий стул 3-8 раз в день с примесью слизи или крови, вздутие живота и повышение температуры. В более тяжелых случаях возможны жалобы на боль при прикосновении к животу, сильная диарея (до 10 и более эпизодов в сутки), тошнота или рвота.
Как проявляется дизентерия у детей?
Дизентерия у детей проявляется интоксикационным (лихорадкой, недомоганием, слабостью, тошнотой) и колитическим синдромами (диареей с примесью крови и слизи, болями в животе, тенезмами). Дизентерию у детей подтверждают данные бактериологического исследования, ПЦР, ИФА, РНГА, копрограммы и ректороманоскопии.
Сколько длится дизентерия у детей?
С учетом характера течения воспалительного процесса выделяют 2 вида дизентерии: острая инфекция (продолжается до 3 месяцев), хроническая инфекция (протекает волнообразно с периодами обострения и ремиссии. Заболевание продолжается дольше 3 месяцев).
Возбудителем дизентерии у детей является?
Дизентерия – это заболевание из группы кишечных инфекционных болезней, возбудителем которого является бактерия Shigella.
Советы
СОВЕТ №1
Обратите внимание на гигиену. Регулярное мытье рук с мылом, особенно после посещения туалета и перед едой, значительно снижает риск заражения дизентерией. Убедитесь, что дети также понимают важность этой практики.
СОВЕТ №2
Следите за качеством воды и пищи. Убедитесь, что вода, которую вы используете для питья и приготовления пищи, безопасна. Избегайте употребления сырых или недостаточно термически обработанных продуктов, особенно в местах с низкими санитарными условиями.
СОВЕТ №3
При появлении симптомов дизентерии, таких как диарея, боли в животе и высокая температура, немедленно обращайтесь к врачу. Раннее обращение за медицинской помощью поможет избежать осложнений и ускорить процесс выздоровления.
СОВЕТ №4
Обеспечьте достаточное количество жидкости. При дизентерии важно поддерживать водный баланс, так как заболевание может привести к обезвоживанию. Пейте много воды, а также растворы для регидратации, чтобы восполнить потерю жидкости и электролитов.